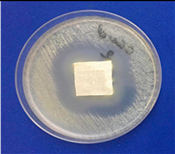
Coatings 11 00159 i004 Coatings 11 00159 i004
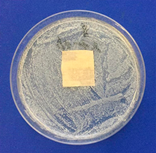
Coatings 11 00159 i005 Coatings 11 00159 i005
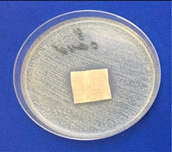
Coatings 11 00159 i006 Coatings 11 00159 i006
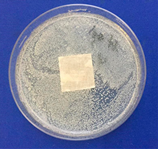
Coatings 11 00159 i007 Coatings 11 00159 i007
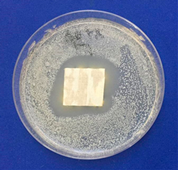
Coatings 11 00159 i008 Coatings 11 00159 i008

Development of Multifunctional Coating of Textile Materials Using Silver Microencapsulated Compositions
Abstract
1. Introduction
2. Materials and Methods
2.1. Materials
2.2. Methods
2.3. Silver Nanoparticles Obtaining Procedure
2.4. Microencapsulation Techniques for Functional Substances
2.4.1. Method of Obtaining Microparticles of Calcium Carbonate
2.4.2. Polyelectrolyte Capsule Shell Synthesis Procedure
2.4.3. Dissolution of Carbonate Cores Method
2.4.4. Determination of the Sensitivity of Microorganisms to Antimicrobial Drugs by the Disk Method (Diffusion Test)
2.4.5. Assessment of Wound Healing on Models of Excisional and Burn Wounds
3. Results
3.1. Protocol for the Synthesis of Biologically Active Substances Nanocapsules of Natural Origin
3.2. Atomic Adsorption Microscopy of Microcapsules Containing Silver Nanoparticles
3.3. Functional Characteristics of Finished Textile Materials
- local inflammatory response;
- results of planimetric studies;
- timing of wound healing;
- determination of the index of acceleration of healing in the experimental groups in relation to self-healing wounds in the control groups.
4. Conclusions
Author Contributions
Funding
Institutional Review Board Statement
Informed Consent Statement
Data Availability Statement
Acknowledgments
Conflicts of Interest
References
- Pinto, R.J.; Marques, P.A.; Neto, C.P.; Trindade, T.; Daina, S.; Sadocco, P. Antibacterial activity of nanocomposites of silver and bacterial or vegetable cellulosic fibers. Acta Biomater. 2009, 5, 2279–2289. [Google Scholar] [CrossRef] [PubMed]
- Krzywicka, A.; Megiel, E. Silver-Polystyrene (Ag/PS) Nanocomposites Doped with Polyvinyl Alcohol (PVA)—Fabrication and Bactericidal Activity. Nanomaterials 2020, 10, 2245. [Google Scholar] [CrossRef]
- Valdés, A.; Ramos, M.; Beltran, A.; Garrigos, M.C. Recent Trends in Microencapsulation for Smart and Active Innovative Textile Products. Curr. Org. Chem. 2018, 22, 1237–1248. [Google Scholar] [CrossRef]
- Ghost, S.K. Functional Coatings by Polymer Microencapsulation; Wiley-VCH: Weinheim, Germany, 2006; p. 378. [Google Scholar]
- Krolevets, A.A.; Tyrsin, Y.A.; Bykovskaya, E.E. Application of nano- and microencapsulation in pharmaceuticals and food industry. Vestnic Rossiiskoy Akademii Estestvennykh Nauk 2013, 1, 77–84. [Google Scholar]
- Cheng, S.Y.; Yuen, C.W.M.; Kan, C.W.; Cheuk, K.K.L. Development of cosmetic textiles using microencapsulation technology. Res. J. Text. Appar. 2008, 12, 41–51. [Google Scholar] [CrossRef]
- Sarma, S.J.; Pakshirajan, K.; Mahanty, B. Chitosan-coated Alginate–polyvinyl Alcohol Beads for Encapsulation of Silicone Oil Containing Pyrene: A Novel Method for Biodegradation of Polycyclic Aromatic Hydrocarbons. J. Chem. Technol. Biotechnol. 2011, 2, 266–272. [Google Scholar] [CrossRef]
- Kumar, B.P.; Chandiran, I.S.; Bhavya, B.; Sindhuri, M. Microparticulate Drug Delivery System: A Review. Indian J. Pharm. Sci. Res. 2011, 1, 19–37. [Google Scholar]
- Borodina, T.N. Obtaining and Research of Biodegradable Polyelectrolyte Microcapsules with Controlled Release of Proteins, DNA and Other Bioactive Compounds. Ph.D thesis, Russian Academy of Sciences, Moscow, Russia, 16 May 2008; p. 119. [Google Scholar]
- Anal, A.K.; Singh, H. Recent Advances in Microencapsulation of Probiotics for Industrial Applications and Targeted Delivery. Trends Food Sci. Technol 2007, 18, 240–251. [Google Scholar] [CrossRef]
- Sanjoy, D. Microencapsulation techniques and its practices. Int. J. Pharm. Sci. Technol. 2011, 6, 1–23. [Google Scholar]
- Silva, P.T.D.; Fries, L.L.M.; Menezes, C.R.D.; Holkem, A.T.; Schwan, C.L.; Wigmann, É.F.; Silva, C.D.B.D. Microencapsulation: Concepts, mechanisms, methods and some applications in food technology. Ciênc. Rural 2014, 44, 1304–1311. [Google Scholar] [CrossRef]
- Salaün, F. Microencapsulation Technology for Smart Textile Coatings; Active Coatings for Smart Textiles; Woodhead Publishing: Southston, UK, 2016; pp. 179–220. [Google Scholar]
- Patel, K.R.; Patel, M.R.; Mehta, T.J.; Patel, A.D.; Patel, N.M. Microencapsulation: Review on novel approaches. Int. J. Pharm. 2011, 648, 894–911. [Google Scholar]
- Donath, E.; Sukhorukov, G.B.; Caruso, F.; Davis, S.A.; Möhwald, H. Novel hollow polymer shells by colloid-templated assembly of polyelectrolytes. Angew. Chem. Int. Ed. 1998, 37, 2201–2205. [Google Scholar] [CrossRef]
- Sukhorukov, G.B.; Donath, E.; Lichtenfeld, H.; Knippel, E.; Knippel, M.; Budde, A.; Möhwald, H. Layer-by-layer self assembly of polyelectrolytes on colloidal particles. Colloids Surf. A: Physicochem. Eng. Asp. 1998, 137, 253–266. [Google Scholar] [CrossRef]
- Iler, R.K. Multilayers of colloidal particles. J. Colloid Interface Sci. 1966, 21, 569–594. [Google Scholar] [CrossRef]
- Decher, G.J.D.H.; Hong, J.D. Buildup of ultrathin multilayer films by a self-assembly process: II. consecutive adsorption of anionic and cationic bipolar amphiphiles on charged surfaces. Macromol. Chem., Macromol. Symp. 1991, 46, 321–327. [Google Scholar] [CrossRef]
- Schuetz, P.; Caruso, F. Copper-assisted weak polyelectrolyte multilayer formation on microspheres and subsequent film crosslinking. Adv. Funct. Mater. 2003, 13, 929–937. [Google Scholar] [CrossRef]
- Volodkin, D.V.; Petrov, A.I.; Prevot, M.; Sukhorukov, G.B. Matrix polyelectrolyte microcapsules: New system for macromolecule encapsulation. Langmuir 2004, 20, 3398–3406. [Google Scholar] [CrossRef]
- Combes, C.; Bareille, R.; Rey, C. Calcium carbonate–calcium phosphate mixed cement compositions for bone reconstruction. J. Biomed. Mater. Res. Part A 2006, 79, 318–328. [Google Scholar] [CrossRef]
- Aisina, R.B.; Kazanskaya, N.F. Microencapsulation of physiologically active substances and their application in medicine. Results of science and technology. Biotechnol. Ser. 1986, 6, 6–52. [Google Scholar]
- Lameiro, M.H.; Lopes, A.; Martins, L.O.; Alves, P.M.; Melo, E. Incorporation of a model protein into chitosan–bile salt microparticles. Int. J. Pharm. 2006, 312, 119–130. [Google Scholar] [CrossRef]
- Grenha, A.; Seijo, B.; Remunán-López, C. Microencapsulated chitosan nanoparticles for lung protein delivery. Eur. J. Pharm. Sci. 2005, 25, 427–437. [Google Scholar] [CrossRef] [PubMed]
- Kozlovskaya, V.; Kharlampieva, E.; Drachuk, I.; Cheng, D.; Tsukruk, V.V. Responsive microcapsule reactors based on hydrogen-bonded tannic acid layer-by-layer assemblies. Soft Matter 2010, 6, 3596–3608. [Google Scholar] [CrossRef]
- Lee, D.; Rubner, M.F.; Cohen, R.E. Formation of nanoparticle-loaded microcapsules based on hydrogen-bonded multilayers. Chem. Mater. 2005, 17, 1099–1105. [Google Scholar] [CrossRef]
- Such, G.K.; Johnston, A.P.R.; Caruso, F. Engineered hydrogen-bonded polymer multilayers: From assembly to biomedical applications. Chem. Soc. Rev. 2010, 40, 19–29. [Google Scholar] [CrossRef] [PubMed]
- Lambert, G.; Fattal, E.; Couvreur, P. Nanoparticulate systems for the delivery of antisense oligonucleotides. Adv. Drug Deliv. Rev. 2001, 47, 99–112. [Google Scholar] [CrossRef]
- Parakhonskiy, B.V.; Bedard, M.F.; Bukreeva, T.V.; Sukhorukov, G.B.; Mohwald, H.; Skirtach, A.G. Nanoparticles on polyelectrolytes at low concentration: Controlling concentration and size. J. Phys. Chem. C 2010, 114, 1996–2002. [Google Scholar] [CrossRef]
- Antipov, A.A.; Sukhorukov, G.B.; Fedutik, Y.A.; Hartmann, J.; Giersig, M.; Möhwald, H. Fabrication of a novel type of metallized colloids and hollow capsules. Langmuir 2002, 18, 6687–6693. [Google Scholar] [CrossRef]
- De Geest, B.G.; Skirtach, A.G.; De Beer, T.R.; Sukhorukov, G.B.; Bracke, L.; Baeyens, W.R.; De Smedt, S.C. Stimuli-Responsive Multilayered Hybrid Nanoparticle/Polyelectrolyte Capsules. Macromol. Rapid Commun. 2007, 28, 88–95. [Google Scholar] [CrossRef]
- Bagaria, H.G.; Kadali, S.B.; Wong, M.S. Shell thickness control of nanoparticle/polymer assembled microcapsules. Chem. Mater. 2010, 23, 301–308. [Google Scholar] [CrossRef]
- Yuan, W.; Lu, Z.; Li, C.M. Controllably layer-by-layer self-assembled polyelectrolytes/nanoparticle blend hollow capsules and their unique properties. J. Mater. Chem. 2011, 21, 5148–5155. [Google Scholar] [CrossRef]
- Radziuk, D.; Skirtach, A.; Sukhorukov, G.; Shchukin, D.; Möhwald, H. Stabilization of silver nanoparticles by polyelectrolytes and poly (ethylene glycol). Macromol. Rapid Commun. 2007, 28, 848–855. [Google Scholar] [CrossRef]
- Skirtach, A.G.; Antipov, A.A.; Shchukin, D.G.; Sukhorukov, G.B. Remote activation of capsules containing Ag nanoparticles and IR dye by laser light. Langmuir 2004, 20, 6988–6992. [Google Scholar] [CrossRef] [PubMed]
- Déjugnat, C.; Sukhorukov, G.B. pH-Responsive Properties of Hollow Polyelectrolyte Microcapsules Templated on Various Cores. Langmuir 2004, 20, 7265–7269. [Google Scholar] [CrossRef] [PubMed]
- Zaikina, N.A.; Kovalenko, A.E.; Galynkin, V.A.; Dyakov, Y.T.; Tishenkov, A.D. Fundamentals of Biotechnology of Higher Fungi: Textbook; Prospekt Nauki: St. Peterburg, Russia, 2007. [Google Scholar]
- Korsun, V.F.; Krasnopolskaya, L.M.; Korsun, E.V.; Avkhukov, M.A. Antitumor Properties of Fungi; Mailer: Moscow, Russia, 2012. [Google Scholar]
- Gerasimenya, V.P.; Zakharov, S.V.; Putyrsky, L.A. Antineoplastic Action of Oyster Mushroom Mycelium Extract. Experimental and Clinical Studies: Information Materials; Issue 3; Inbiopharm LLC: Moscow, Russia, 2009. [Google Scholar]
- Mauser, T.; Déjugnat, C.; Sukhorukov, G.B. Reversible pH-dependent properties of multilayer microcapsules made of weak polyelectrolytes. Macromol. Rapid Commun. 2004, 25, 1781–1785. [Google Scholar] [CrossRef]
- GOST 3816-81 (ISO 811-81) Textile Fabrics. Methods for Determining Hygroscopic and Water-Repellent Properties; IPK Publishing House of Standards: Moscow, Russia, 1998. [Google Scholar]

| Indicators | Value of Indicators | ||||||
|---|---|---|---|---|---|---|---|
| Stirring time of the reaction mixture, min | 0.5 | 1.5 | 3 | 4 | 5 | 6 | 10 |
| Dimensional characteristics of CaCO3 particles, μm | 8.68 | 8.6 | 7.77 | 7.68 | 6.96 | 6.96 | 6.96 |
| No. | Photographs of Particles Obtained Using a Microscope “Micromed 1” | Method for Obtaining Capsules | Particle Size Distribution | |
|---|---|---|---|---|
| Particle Size, nm | Percentage, % | |||
| 1 | ![]() | 1.1 1.0 g of calcium carbonate particles were treated for 20 min in a solution of chitosan with a concentration of 0.1%; - rinsing with water; - impregnation with a solution of xanthan gum 0.05% 20 min; - rinsing with water; 1.2. dissolution of the core. | 9.7 316.1 7597.0 | 0.1 24.6 75.3 |
| 2 | ![]() | 2.1. as in item 1.1 2.2. chitosan layer (according to the technology above); -rinsing with water; 2.3. dissolution of the core; 2.4. acidification and injection of 100 μL BAS; -stirring and neutralization with sodium hydroxide. | 496.0 909.7 7989.0 | 0.4 78.5 21.1 |
| 3 | ![]() | The lifetime of the system prepared according to the developed method is 6 days. | 522.0 922.8 7998.1 | 2.0 97.2 0.8 |
| Microorganism | Photo of Results/Zone of Delay, mm | |
|---|---|---|
| With Silver | Without Silver | |
| Staphylococcus aureus—a spherical, immobile, aerobic (airborne) bacterium, positively stained according to Gram, which causes various diseases in children and adults. | ![]() 8 mm | ![]() 0 mm |
| Escherichia coli—a type of gram-negative rod-shaped bacteria, widespread in the lower intestines of warm-blooded animals. However, among E. coli, there are also species that can cause various infectious diseases in humans, ranging from common intestinal disorders to sepsis. | ![]() 3 mm | ![]() 0 mm |
| Candida albicans is a diploid fungus, pathogen, anaerobic microorganism. It may be a consequence and an etiological factor of the occurrence of multiple human infections. | ![]() 13 mm | ![]() 2 mm |
| Model | The Beginning of Wound Treatment | Drug Concentration, mg/L | Number of Animals | Percentage of Healing Relative to the Primary Wound,% | Healing Acceleration Index,% | |||||
|---|---|---|---|---|---|---|---|---|---|---|
| Day from Model Creation | 4 | 8 | 11 | 15 | 18 | 22 | - | |||
| Burn wound | From the first day | - | 1 | 0 | 0 | 0 | 23.1 | 38.5 | 53.9 | - |
| 1.75 | 1 | 0 | 0 | 0 | 7.6 | 30.8 | 46.2 | –14.3 | ||
| 3.84 | 1 | 0 | 0 | 0 | 0 | 30.8 | 46.2 | –14.3 | ||
| 5.93 | 2 | 0 | 0 | 0 | 11.6 | 29.7 | 44.6 | –17.3 | ||
| 8.01 | 2 | 0 | 0 | 0 | 14.3 | 27.4 | 56.6 | +5.0 | ||
| 10.1 | 2 | 3.6 | 3.6 | 21.4 | 26.2 | 42 | 57.1 | +5.9 | ||
| Excision wound | From the first day | - | 1 | 0 | 35.7 | 57.1 | 85.7 | 85.7 | 85.7 | - |
| 1.75 | 1 | 0 | 33.3 | 50.0 | 66.7 | 75,0 | 83.3 | –2.8 | ||
| 3.84 | 1 | 0 | 41.7 | 66.7 | 83.3 | 91.7 | 91.7 | +7.0 | ||
| 5.93 | 2 | 3.6 | 47.8 | 64.0 | 73.1 | 77.6 | 92.3 | +7.7 | ||
| 8.01 | 2 | 0 | 28.7 | 48.7 | 74.3 | 87.6 | 100 | +16.7 | ||
| 10.1 | 2 | 0 | 45.0 | 55.8 | 78.3 | 90.0 | 100 | +16.7 | ||
| Excision wound + staphylococcus | From the first day | - | 2 | 0 | 46.5 | 60.7 | 75.0 | 92.9 | 92.9 | - |
| 1.75 | 1 | 7.1 | 42.9 | 71.4 | 78.6 | 85.7 | 92.9 | 0 | ||
| 3.84 | 2 | 9.8 | 46.9 | 63.4 | 89.8 | 93.2 | 96.9 | +4.3 | ||
| 5.93 | 2 | 0 | 30.8 | 61.4 | 80.8 | 84.6 | 92.3 | –0.6 | ||
| 8.01 | 2 | 0 | 37.5 | 62.6 | 93.8 | 100 | 100 | +7.6 | ||
| From the fifth day | 1.75 | 1 | 0 | 30.8 | 38.5 | 69.2 | 84.6 | 92.3 | –0.7 | |
| 3.84 | 1 | 0 | 40.0 | 60.0 | 66.7 | 100 | 100 | +7.6 | ||
| 5.93 | 2 | 0 | 37.3 | 61.4 | 92.3 | 92.3 | 96.2 | +3.6 | ||
| 8.01 | 2 | 0 | 25.0 | 31.3 | 43.8 | 56.3 | 75.1 | –19.2 | ||
Publisher’s Note: MDPI stays neutral with regard to jurisdictional claims in published maps and institutional affiliations. |
© 2021 by the authors. Licensee MDPI, Basel, Switzerland. This article is an open access article distributed under the terms and conditions of the Creative Commons Attribution (CC BY) license (http://creativecommons.org/licenses/by/4.0/).
Share and Cite
Petrova, L.; Kozlova, O.; Vladimirtseva, E.; Smirnova, S.; Lipina, A.; Odintsova, O. Development of Multifunctional Coating of Textile Materials Using Silver Microencapsulated Compositions. Coatings 2021, 11, 159. https://doi.org/10.3390/coatings11020159
Petrova L, Kozlova O, Vladimirtseva E, Smirnova S, Lipina A, Odintsova O. Development of Multifunctional Coating of Textile Materials Using Silver Microencapsulated Compositions. Coatings. 2021; 11(2):159. https://doi.org/10.3390/coatings11020159
Chicago/Turabian StylePetrova, Luidmila, Olga Kozlova, Elena Vladimirtseva, Svetlana Smirnova, Anna Lipina, and Olga Odintsova. 2021. "Development of Multifunctional Coating of Textile Materials Using Silver Microencapsulated Compositions" Coatings 11, no. 2: 159. https://doi.org/10.3390/coatings11020159
APA StylePetrova, L., Kozlova, O., Vladimirtseva, E., Smirnova, S., Lipina, A., & Odintsova, O. (2021). Development of Multifunctional Coating of Textile Materials Using Silver Microencapsulated Compositions. Coatings, 11(2), 159. https://doi.org/10.3390/coatings11020159